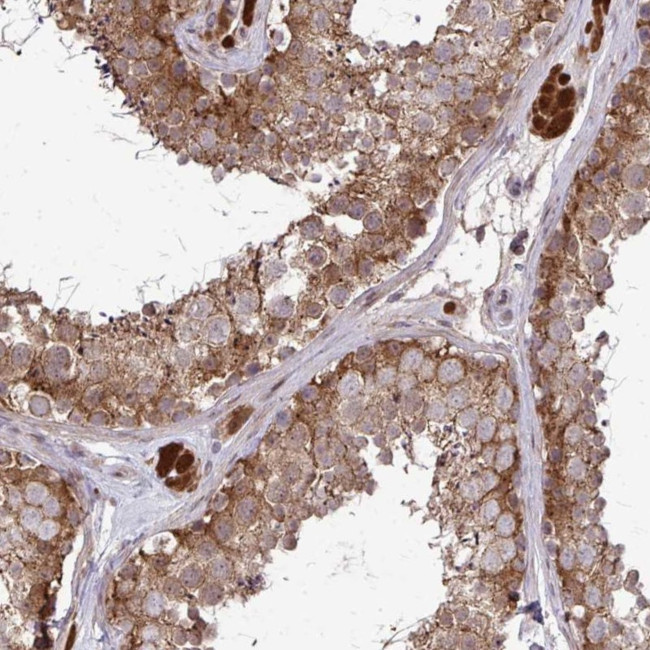
CCS Antibody in Immunohistochemistry (Paraffin) (IHC (P))

Search
Invitrogen
CCS Polyclonal Antibody
{{$productOrderCtrl.translations['antibody.pdp.commerceCard.promotion.promotions']}}
{{$productOrderCtrl.translations['antibody.pdp.commerceCard.promotion.viewpromo']}}
{{$productOrderCtrl.translations['antibody.pdp.commerceCard.promotion.promocode']}}: {{promo.promoCode}} {{promo.promoTitle}} {{promo.promoDescription}}. {{$productOrderCtrl.translations['antibody.pdp.commerceCard.promotion.learnmore']}}
产品信息
PA5-83703
种属反应
宿主/亚型
分类
类型
抗原
偶联物
形式
浓度
规格
纯化类型
保存液
内含物
保存条件
运输条件
RRID
产品详细信息
Immunogen sequence: GQLQNLGAAV AILGGPGTVQ GVVRFLQLTP ERCLIEGTID GLEPGLHGLH VHQYGDLTNN CNSCGNHFNP DGASHGGPQD SDRHR
Highest antigen sequence indentity to the following orthologs: Rat - 84%, Mouse - 86%.
靶标信息
Superoxide dismutase (SOD) is an antioxidant enzyme involved in the defense system against reactive oxygen species (ROS). SOD catalyzes the dismutation reaction of superoxide radical anion (O2) to hydrogen peroxide, which is then catalyzed to innocuous O2 and H2O by glutathione peroxidase and catalase. Several classes of SOD have been identified. These include intracellular copper, zinc SOD (Cu, Zn-SOD/SOD-1), mitochondrial manganese SOD (Mn-SOD/SOD-2) and extracellular Cu, Zn-SOD (EC-SOD/SOD-3). SOD1 is found in all eukaryotic species as a homodimeric 32 kDa enzyme containing one each of Cu and Zn ion per subunit. The manganese containing 80 kDa tetrameric enzyme SOD2, is located in the mitochondrial matrix in close proximity to a primary endogenous source of superoxide, the mitochondrial respiratory chain. SOD3 is a heparin-binding multimer of disulfide-linked dimers, primarily expressed in human lungs, vessel walls and airways. SOD4 is a copper chaperone for superoxide dismutase (CCS), which specifically delivers Cu to copper/zinc superoxide dismutase. CCS may activate copper/zinc superoxide dismutase through direct insertion of the Cu cofactor.
仅用于科研。不用于诊断过程。未经明确授权不得转售。
篇参考文献 (0)
生物信息学
蛋白别名: capsanthin-capsorubin synthase; CCS; Copper chaperone for superoxide dismutase; ketoxanthophyll synthase; Superoxide dismutase copper chaperone
基因别名: CCS
UniProt ID: (Human) O14618
Entrez Gene ID: (Human) 9973